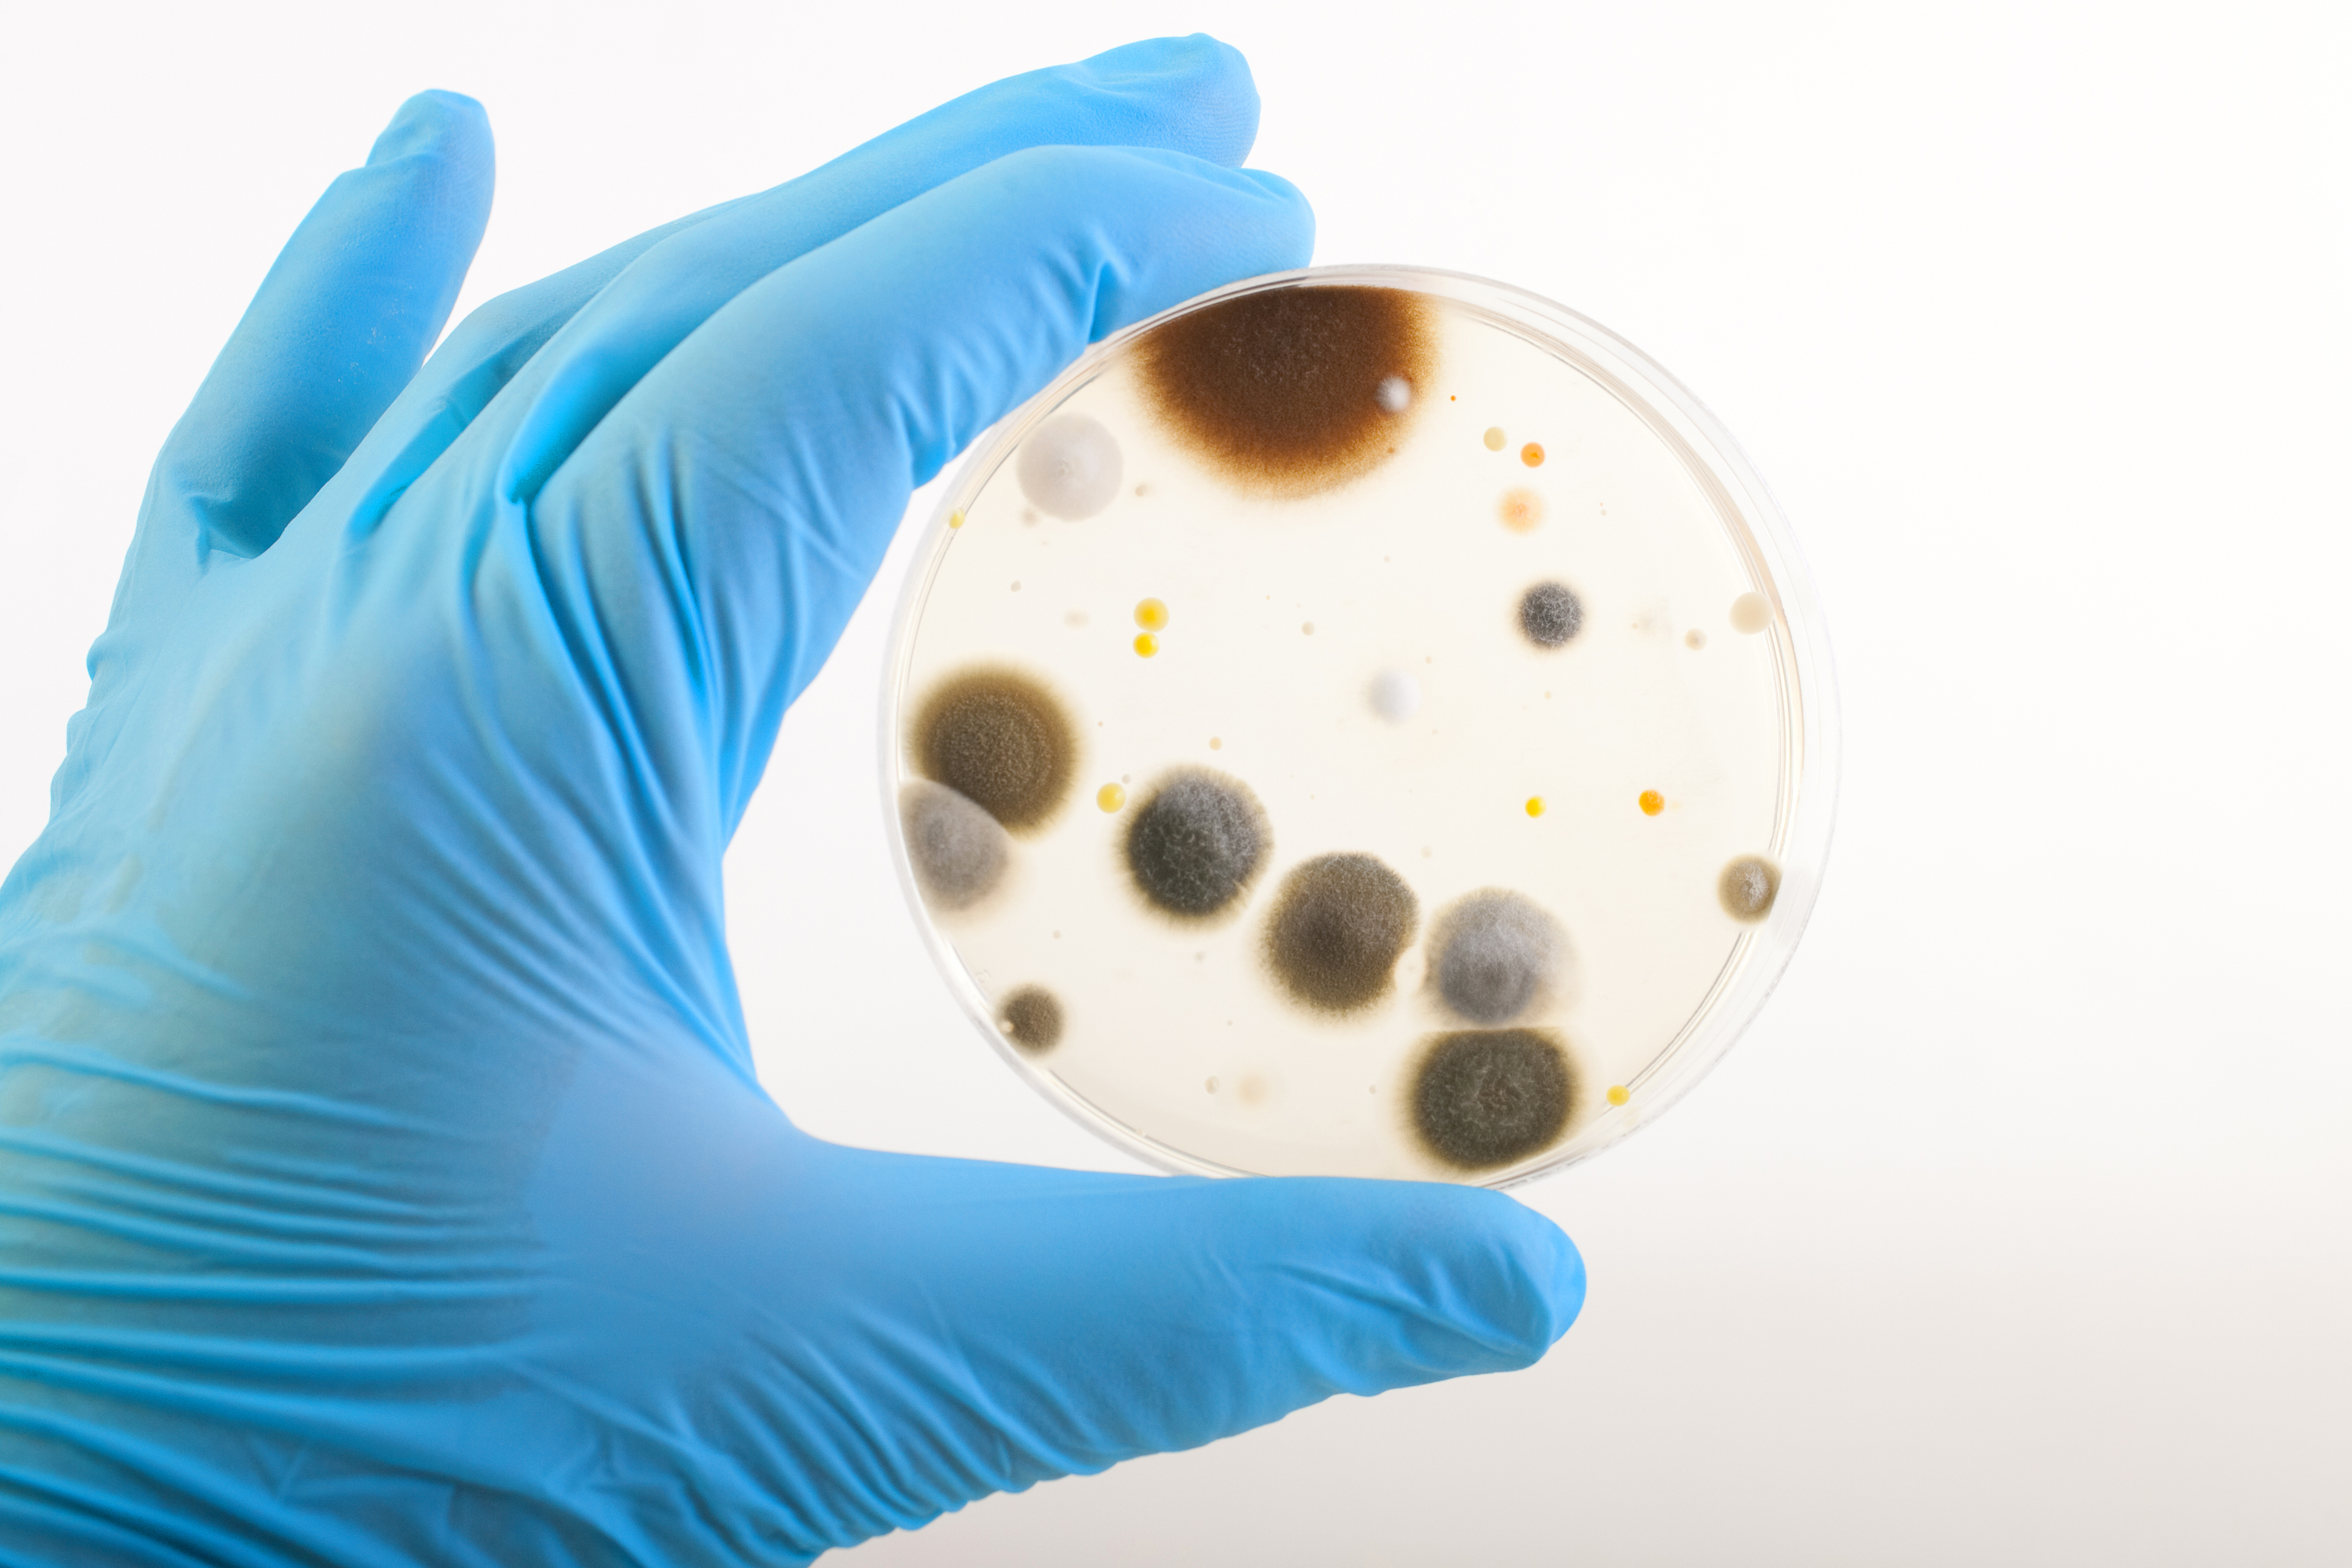
schimmelcultuur in petrischaal

High Care = streng toezicht
De term High Care slaat op die productieruimten waar de meest hoge eisen van toepassing zijn. Dit, om de kritische producten, de producten die geen hittebehandeling meer ondergaan voordat ze worden geconsumeerd, te beschermen.
Staalafnames doen in een dergelijke omgeving in de voedingscontext is in de praktijk een moeilijke operatie, wegens duur en tijdrovend. Werken met mathematische voorspellingen om op basis daarvan het risico te gaan bepalen, blijft werken in een grijze zone.
‘Omgeving’?
Wat je onder ‘de omgeving‘ moet verstaan is ook ruim interpreteerbaar maar niet te verwaarlozen. Wat met microbiële groei binnen luchtafzuigingssystemen of wederkerende schimmels op muren en plafonds: moeilijk bereikbaar of niet prioritair binnen de productieketen? Tijdens controles en audits wordt hier dan ook vaak stilzwijgend aan voorbij gegaan…
Listeria
Maar wat bijvoorbeeld met Listeria Monocytogenes-besmettingen? Een bacterie die zich ontwikkelt bij lage temperaturen (ook in koelcellen), maar even goed in productieruimtes, waardoor de besmetting zich overal en onopgemerkt kan voordoen. Wat kan een producent hiertegen beginnen?
Als we niet alleen bacteriën en virussen willen afdoden, maar (binnen vochtige omgevingen) ook schimmels willen bestrijden, gaan we richting totale desinfectie. Een totale desinfectie via verneveling kan complex lijken, maar kan in de praktijk met één druk op de knop opgestart worden.
Als we niet alleen bacteriën en virussen willen afdoden, maar (binnen vochtige omgevingen) ook schimmels willen bestrijden, gaan we richting totale desinfectie. Een totale desinfectie via verneveling kan complex lijken, maar kan in de praktijk met één druk op de knop opgestart worden.
Kent u de beperkingen van manuele desinfectie?
Download het GRATIS E-Book!
Het vernevelen van Quads is een mogelijkheid, maar door lange afbraaktijden kan dat onmogelijk dagelijks gebeuren. Hierbij geldt bovendien de noodzaak van een goede naspoeling, hetgeen de waterfactuur verder de hoogte in jaagt en ruimte laat voor menselijke fouten.
Automatisch en zonder residu?
Waterstofperoxide vernevelen (fogging) zou een oplossing kunnen bieden als men de juiste technologie gaat gebruiken. Vernevelen van waterstofperoxide in combinatie met perazijnzuur duurt alweer langer, omdat er 2 chemische bestandsdelen afgebroken moeten worden.
Het droog vernevelen van waterstofperoxide is het meest aangewezen, dankzij de korte contact– en afbraaktijden. Elk vrij oppervlak wordt behandeld, ook de luchtafzuigingssystemen (vaak een broeihaard aan ziektekiemen). De hele ruimte wordt zo ontsmet en verdere uitgroei efficiënt voorkomen.



